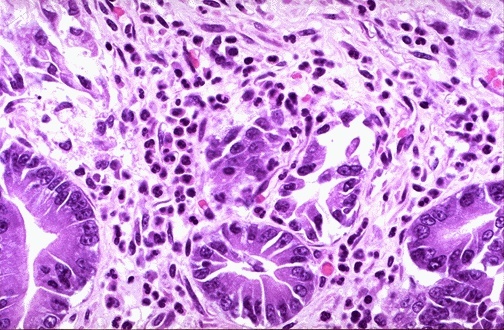
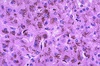

Normal non-keratinizing esophageal squamous mucosa is seen here at the left, and there is underlying submucosa containing mucus glands, with a duct surrounded by lymphoid tissue. At the right is the muscularis with smooth muscle as well as outer skeletal muscle.

Acute esophagitis is manifested here by increased neutrophils in the submucosa as well as neutrophils infiltrating into the squamous mucosa at the right. The acute inflammation can be caused by infections, ingestion of irritative chemicals, drugs such as NSAIDS, chemotherapy, and radiation.

The lower esophagus here shows sharply demarcated ulcerations that have a brown-red base, contrasted with the normal pale white esophageal mucosa at the far left. Such “punched out” ulcers are suggestive of herpes simplex infection.

A herpetic ulcer is seen microscopically to have a sharp margin. The ulcer base at the left shows loss of overlying squamous epithelium with only necrotic debris remaining. In the upper GI endoscopic view below, there are rounded, erythematous ulcerations of the lower esophagus. Biopsies of these lesions reveals intranuclear inclusions in squamous epithelial cells indicative of herpes simplex virus esophagitis. This patient was immune compromised from chemotherapy.

At high magnification, the squamous mucosa at the margin of the herpetic ulcer shows pale pink “ground glass” inclusions within squamous epithelial cells. Some of the inclusions are clustered together– multinucleation is another common viral cytopathic effect.

A common cause for inflammation is a so-called “Barrett esophagus” with epithelial metaplasia to gastric-type mucosa above the gastroesophageal junction. The metaplasia results from chronic gastroesophageal reflux disease (GERD). Note the columnar epithelium to the left and the squamous epithelium at the right. This is “typical” Barrett mucosa, because there is intestinal metaplasia as well (note the goblet cells in the columnar mucosa).

These two endoscopic views demonstrate Barrett esophagus areas of mucosal erythema of the lower esophagus, with islands of normal pale esophageal squamous mucosa. If the area of Barrett mucosa extends less than 2 cm above the normal squamocolumnar junction, then the condition is called “short segment” Barrett esophagus, as shown below.

A history of smoking and/or alcoholism is often present in patients with esophageal squamous carcinoma, while a history of Barrett esophagus precedes development of esophageal adenocarcinoma in many cases. Here, an ill-defined mass at the gastroesophageal junction produces mucosal ulceration and irregularity, which led to the clinical symptoms of pain and difficulty swallowing.

At the upper left is a remnant of squamous esophageal mucosa that has been undermined by an infiltrating squamous cell carcinoma of the mid-esophagus. Solid nests of neoplastic cells are infiltrating down through the submucosa at the right. Esophageal cancers often spread to surrounding structures, making surgical removal difficult.

At high power, these infiltrating nests of neoplastic cells have abundant pink cytoplasm and distinct cell borders typical for squamous cell carcinoma. Esophageal carcinomas are not usually detected early and, therefore, have a very poor prognosis

This is the normal appearance of the gastric fundal mucosa, with short pits lined by pale columnar mucus cells leading into long glands which contain bright pink parietal cells that secrete hydrochloric acid.

This is a more typical acute gastritis with a diffusely hyperemic gastric mucosa. There are many causes for acute gastritis: alcoholism, drugs, infections, etc.

Here are some larger areas of gastric hemorrhage that could best be termed “erosions” because the superficial mucosa is eroded away. Such erosions are typical for the pathologic process termed gastropathy, which describes gastric mucosal injury without significant inflammation. The findings here fit with acute erosive gastropathy, but there are other patterns. Etiologies for the various gastropathies can include: alcohol, drugs such as NSAIDS, stress, uremia, bile reflux, portal hypertension, radiation, and chemotherapy.
On microscopic examination at high power, this gastric mucosa shows infiltration by neutrophils. This is acute gastritis.

Microscopically, the ulcer here is sharply demarcated, with normal gastric mucosa on the left falling away into a deep ulcer whose base contains infamed, necrotic debris. An arterial branch at the ulcer base is eroded and bleeding.

The mucosa at the upper right merges into the ulcer at the left which is eroding through the mucosa. Ulcers will penetrate over time if they do not heal. Penetration leads to pain. If the ulcer penetrates through the muscularis and through adventitia, then the ulcer is said to “perforate” and leads to an acute abdomen. An abdominal radiograph may demonstrate free air with a perforation.

Chronic gastritis and peptic ulcer disease are often accompanied by infection with Helicobacter pylori. This small curved to spiral rod-shaped bacterium is found in the surface epithelial mucus of most patients with active gastritis. The rod-shaped bacteria are seen here with a methylene blue stain.

Another association with gastritis is pernicious anemia. Chronic atrophic gastritis is associated with autoantibodies that block or bind intrinsic factor. Another type of autoantibody demonstrated here is anti-parietal cell antibody. The bright green immunofluorescence is seen in the paritetal cells of the gastric mucosa.

The stomach is opened here to reveal a gastric adenocarcinoma In the U.S., most gastric cancers are discovered at a late stage when the neoplasm has invaded and/or metastasized. In Japan, where the incidence of gastric cancer is high, endoscopic screening is conducted, and more cancers are detected at an early stage. ALL gastric ulcers and ALL gastric masses must be biopsied, because it is not possible to tell from gross appearance alone which are benign and which are malignant. In contrast, virtually all duodenal peptic ulcers are benign.

This is an example of linitis plastica, a diffuse infiltrative gastric adenocarcinoma which gives the stomach a shrunken “leather bottle” appearance with extensive mucosal erosion and a markedly thickened gastric wall. This type of carcinoma has a very poor prognosis. The endoscopic view of this lesion is shown below, with extensive mucosal erosion.

A moderately differentiated gastric adenocarcinoma is infiltrating up and into the submucosa below the squamous mucosa of the esophagus. The neoplastic glands are variably sized.

At higher magnification, the infiltrating neoplastic glands of gastric adenocarcinoma show mitoses, increased nuclear/cytoplasmic ratios, and hyperchromatism. There is a desmoplastic stromal reaction to the infiltrating glands.

At high power, this gastric adenocarcinoma is so poorly differentiated that glands are not visible. Instead, rows of infiltrating neoplastic cells with marked pleomorphism are seen. Many of the neoplastic cells have clear vacuoles of mucin pushing the cell nucleus to one side, giving them a ‘signet ring’ appearance.

This is a signet ring cell pattern of adenocarcinoma in which the cells are filled with mucin vacuoles that push the nucleus to one side, as shown at the arrow.